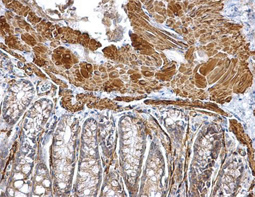
alpha Smooth Muscle Actin antibody

|
Epithelial-mesenchymal transition (EMT) is a process whereby largely adherent and polarized epithelial cells acquire the phenotype of more mobile mesenchymal cells. EMT not only facilitates morphogenesis during embryonic development but also promotes invasion and metastasis in tumors. Pathological EMT is associated with E-cadherin repression, which has been shown to contribute to tumor progression. Several oncogenic pathways (e.g., TGF-beta, Wnt/beta-catenin, integrins, and Notch) have been reported to induce EMT via cytoskeleton rearrangement and activation of E-cadherin repressors, including Snail, Slug, SIP1, ZEB1, and TCF3.
|
EMT-inducing Transcription Factors |
|
|
|
||||||||||||
|
Epithelial Markers |
|
|
|
||||||||||||
|
Mesenchymal Markers |
|
|
|
||||||||||||